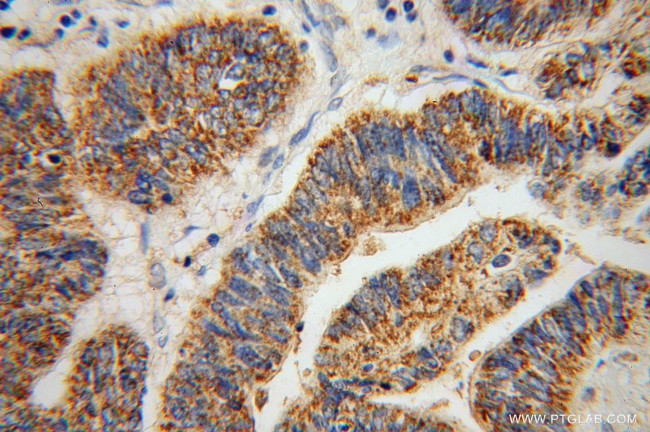
ABCG4 Antibody in Immunohistochemistry (Paraffin) (IHC (P))
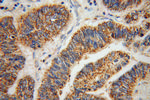
ABCG4 Antibody in Immunohistochemistry (Paraffin) (IHC (P))

Search
Proteintech
ABCG4 Polyclonal Antibody
{{$productOrderCtrl.translations['antibody.pdp.commerceCard.promotion.promotions']}}
{{$productOrderCtrl.translations['antibody.pdp.commerceCard.promotion.viewpromo']}}
{{$productOrderCtrl.translations['antibody.pdp.commerceCard.promotion.promocode']}}: {{promo.promoCode}} {{promo.promoTitle}} {{promo.promoDescription}}. {{$productOrderCtrl.translations['antibody.pdp.commerceCard.promotion.learnmore']}}
产品信息
14269-1-AP
种属反应
已发表种属
宿主/亚型
分类
类型
抗原
偶联物
形式
浓度
规格
纯化类型
保存液
内含物
保存条件
运输条件
产品详细信息
Immunogen sequence: MAEKALEAV GCGLGPGAVA MAVTLEDGAE PPVLTTHLKK VENHITEAQR FSHLPKRSAV DIEFVELSYS VREGPCWRKR GYKTLLKCLS GKFCRRELIG IMGPSGAGKS TFMNILAGYR ESGMKGQILV NGRPRELRTF RKMSCYIMQD DMLLPHLTVL EAMMVSANLK LSEKQEVKKE LVTEILTALG LMSCSHTRTA LLSGGQRKRL AIALELVNNP PVMFFDEPTS GLDSASCFQV VSLMKSLAQG GRTIICTIHQ PSAKLFEMFD KLYILSQGQC IFKGVVTNLI PYLKGLGLHC PTYHNPADFI IEVASGEYGD LNPMLFRAVQ NGLCAMAEKK SSPEKNEVPA PCPPCPP (1-356 aa encoded by BC041091)
靶标信息
The ABCG4 gene encodes the ATP-binding cassette sub-family G member 4, a protein that is part of the ABC transporter family involved in the transport of various molecules across cellular membranes. ABC transporters play essential roles in lipid transport, drug resistance, and the maintenance of cellular homeostasis. ABCG4, specifically, is known to be involved in the transport of cholesterol and other lipids, influencing lipid homeostasis and potentially impacting processes such as cholesterol efflux and cellular lipid balance. This protein is expressed in specific tissues, including the brain and retina, indicating its role in neuronal lipid metabolism and health. While its exact physiological functions are still being elucidated, alterations in ABCG4 expression or function may be implicated in lipid-related disorders and neurodegenerative diseases, where lipid metabolism plays a crucial part. Research into ABCG4 focuses on understanding its transport mechanisms and potential contributions to pathological states, aiming to develop targeted therapies that address imbalances in lipid and cholesterol metabolism.
仅用于科研。不用于诊断过程。未经明确授权不得转售。
生物信息学
蛋白别名: ATP-binding cassette sub-family G member 4; ATP-binding cassette subfamily G member 4; ATP-binding cassette transporter White2; ATP-binding cassette, sub-family G (WHITE), member 4; putative ABC transporter; unnamed protein product
基因别名: 6430517O04Rik; ABCG4; WHITE2
UniProt ID: (Human) Q9H172, (Mouse) Q91WA9, (Rat) D3ZCM3
Entrez Gene ID: (Human) 64137, (Mouse) 192663, (Rat) 300664